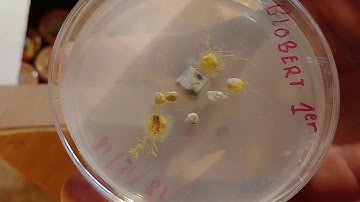
Pétri express, et transfert de Blob. J+3 - Blob 4

⬇ DOWNLOAD NOW
Kalau muncul iklan pop-up, tutup lalu klik tombol kembali
Download lagu Culture de Blob J+1, c'est parti! - Blob 3 secara gratis hanya untuk keperluan promosi. Dukung artis favorit kamu dengan membeli musik original di iTunes atau platform resmi lainnya.
 De Blob: een lerende cel | CNRS Nieuws
De Blob: een lerende cel | CNRS Nieuws
 🟡 Le Journal du blob - Le labyrinthe
🟡 Le Journal du blob - Le labyrinthe
 Doodling A Self Portrait! | Mr Doodle
Doodling A Self Portrait! | Mr Doodle
 Italian Brainrot Pat Rahmat Mamat Literal Vs Reality Compound Words
Italian Brainrot Pat Rahmat Mamat Literal Vs Reality Compound Words
 I'm starting to breed BLOBs!!
I'm starting to breed BLOBs!!
 Jester's Sad and Happy Side Transformation | Garten of Banban #animation
Jester's Sad and Happy Side Transformation | Garten of Banban #animation
Pétri express, et transfert de Blob. J+3 - Blob 4
Pétri express, et transfert de Blob. J+3 - Blob 4
 Blob - indecision
Blob - indecision